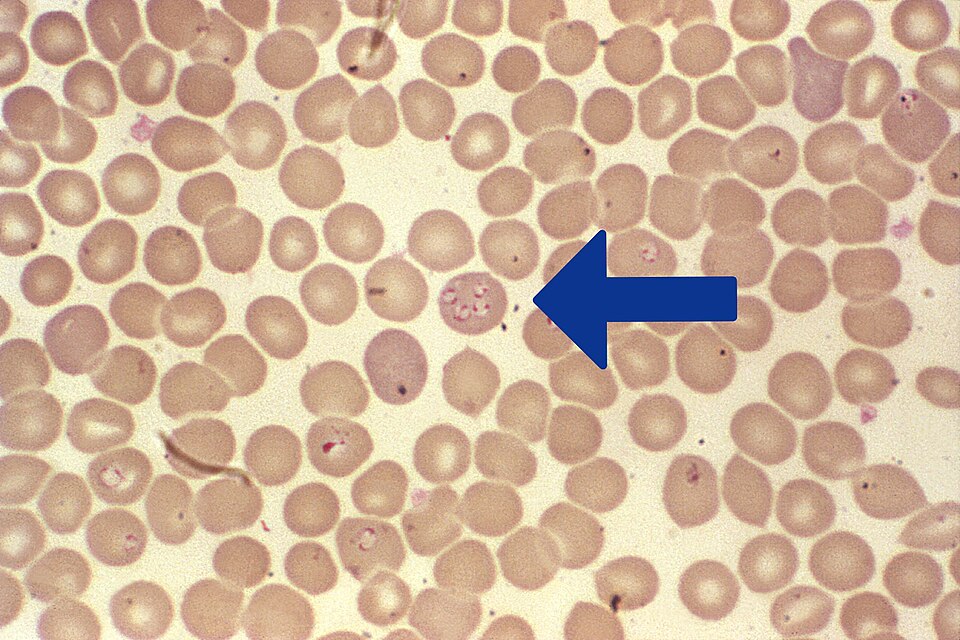

Babesióza
| Babesióza | |
| Anglicky: | babesiosis |
|---|---|
| Latinsky: | |
| Typ: | infekčná |
| Subtyp: | parazitická |
| Pôvodca: | prvok Babesia |
| Symptómy: | obvykle bez, prípadne horúčka a hnačka |
| Terapia: | |
| Prevencia: | |
| ICD-9: | http://www.icd9data.com/getICD9Code.ashx?icd9=088.82 |
| ICD-10: | http://apps.who.int/classifications/icd10/browse/2010/en#/B60.0 |
| DiseasesDB: | http://www.diseasesdatabase.com/ddb1200.htm |
| MedlinePlus: | |
| eMedicine: | |
| MeSH: | http://www.nlm.nih.gov/cgi/mesh/2013/MB_cgi?field=uid&term=D001404 |
| OMIM: | |
| Zdroj: https://en.wikipedia.org/wiki/Babesiosis | |
Babesióza je parazitická choroba spôsobená prvokom Babesia, čo je rod protozoálnych piroplazmidov. Po trypanozómach je Babesia druhým najčastejším parazitom v krvi cicavcov a môže mať veľký dopad na zdravie domácich zvierat v oblastiach bez tuhých zím. Babesióza u človeka je zriedkavá, ale reportované prípady v súčasnosti narastajú pre pokročilé medické vyšetrenia.
Symptómy a znaky
Väčšina infekcií Babesiou je asymptomatická, ale môže zahrnovať mierne horúčky a hnačky. Symptómy sú často prehliadnuté alebo nevysvetlené. V najvážnejších prípadoch sú symptómy podobné malárii s horúčkami do 40,5°C, trasenie od zimy a silná anémia (hemolytická anémia). Môže nasledovať zlyhanie orgánov včetne syndrómu respiračnej bolesti dospelých. Vážne prípady nastávajú najviac u ľudí, ktorý nemajú slezinu a u veľmi mladých, starých a s oslabenou imunitou.
Reportovaný nárast prípadov babesiózy po roku 2000 sa vysvetľuje častejším testovaním a vyšším počtom ľudí so zníženou imunitou, ktorí prichádzajú do kontaktu s kliešťami, vektormi (prenášačmi) choroby. Málo je známe o výskyte druhov Babesia v oblastiach endemických na maláriu, kde môže byť Babesia ľahko diagnostikovaná ako Plasmodium.
Zdroj
https://en.wikipedia.org/wiki/Babesiosis
Kategória: Infekčné choroby
AIDS – s AIDS súvisiaci komplex – nepravé kiahne (Varicella) – prechladnutie – cytomegalovírus - herpesová infekcia – horúčka dengue – Ebolová hemoragická horúčka – choroba rúk, nôh a úst – hepatitída – Herpes simplex – Herpes zoster – ľudský papilomavírus (HPV) – chrípka (Flu) – Lassavská horúčka – osýpky – Marburgská hemoragická horúčka – infekčná mononukleóza – mumps – detská obrna – progresívna multifokálna leukencefalopatia – besnota – rubeola – silný akútny respiračný syndróm (SARS) – pravé kiahne (Variola) – vírusová encefalitída (zápal mozgu) – vírusová gastroenteritída – vírusová meningitída (zápal mozgových blán) – vírusová pneumónia (zápal pľúc)– západonílska choroba – žltá horúčka
antraxová choroba – bakteriálna meningitída – botulizmus – brucelóza – campylobakterióza – choroba z mačacieho škrabnutia – cholera – záškrt (diftéria)– epidemický týfus – lišaj (impetigo)– legionelóza – lepra (malomocenstvo) – leptospiróza – listerióza – borelióza (Lymská choroba)– melioidóza – infekcia MRSA (Meticilín-Rezistentný Stafylokokus Aureus)– nokardióza – čierny kašel – mor – pneumokoková pneumónia – psitakóza – horúčka Q – horúčka Skalnatých hôr – salmonelóza – šarlach – šigelóza – syfilis – tetanus – trachóma (chronická choroba spojiviek)– tuberkulóza – tularémia – brušný týfus (škvrnitý týfus)– týfus– infekcie močového traktu
africká spavá choroba – amebiáza – askarióza – babesióza – Chagasova choroba – klonorchióza – kryptosporidióza – cysticerkóza – difylobotriáza – dracunculiáza – echinokokóza – enterobióza – fasciolóza – fasciolopsiáza – filarióza – giardiáza – gnatostomiáza (infekcia čelustí) – hymenolepióza – isosporóza – Kala-azar – leishmanióza – malária – metagonimiáza – myiáza – onchocerciáza – pedikulóza (zavšivavenie) – svrab – schistosomiáza – pásomnicová infekcia (taeniáza) – toxokaróza – toxoplazmóza – trichinelóza – trichinóza – trichuriáza – trichomoniáza – spavá choroba (trypanosomiáza)
aspergilóza – blastomykóza – kandidóza (opar) – kokcidioidomykóza – kryptokokóza – histoplazmóza – tinea pedis
prenosná spongiformná encefalopatia – Creutzfeldt-Jakobova choroba – kuru (infekcia CNS) – fatálna rodinná nespavosť (insomnia)
- Ďalšie články
Baktéria Infekcia Infekčná choroba Sepsa Vírus Zoznam infekčných chorôb
